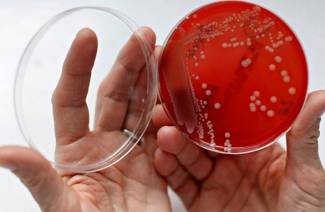

Jak leczyć jęczmień w oku

Gorączka krwotoczna z zespołem nerkowym: objawy i leczenie

Infekcja enterowirusowa - objawy u dzieci i dorosłych, metody leczenia

Rodzaje zatrucia ludzkiego ciała
Ważne jest rozpoznanie rodzajów zatrucia, aby zapewnić odpowiednią opiekę medyczną na czas. Dowiedz się więcej o klasyfikacji zatrucia, ponieważ ...

Leczenie tężca u ludzi: objawy i diagnoza choroby
Zapobieganie i leczenie tężca to podstawowe zasady. Dowiedz się, jak możesz dostać tę chorobę, jakie środki należy podjąć, gdy ...

Jersinioza - objawy i objawy na różnych etapach choroby
Niebezpieczną infekcją przenoszoną na ludzi ze zwierząt jest żółtaczka - objawy choroby są bardzo zróżnicowane. Sprawdź szczegóły ...

Ludzka anaplazmoza granulocytowa - objawy choroby

Oznaki ludzkiego zapalenia mózgu: objawy po ukąszeniu kleszcza

Objawy zapalenia mózgu u ludzi - pierwsze oznaki i formy choroby
Objawy zapalenia mózgu u ludzi różnią się w zależności od postaci choroby. Dowiedz się, jak infekcja objawia się na różnych etapach choroby, ...

Jakie choroby przenoszą kleszcze?
Dowiedz się, jakie choroby przenoszą kleszcze. Większość zakażeń kleszczowych jest bardzo niebezpieczna dla ludzi, dlatego ważne jest, aby poznać ich główne odmiany ...

Grzyby w moczu: przyczyny i leczenie

Schemat leczenia lekami chlamydiami

Streptococcus zapalenie płuc: objawy i leczenie

Streptococcus w moczu - przyczyny pojawienia się, sposoby i warunki zakażenia, diagnoza, metody leczenia

Streptococcus agalactia u mężczyzn i kobiet

Streptococcus grupa A - rodzaje bakterii, drogi zakażenia i objawy, diagnoza, metody leczenia dzieci i dorosłych

Streptococcus viridans: leczenie u ludzi